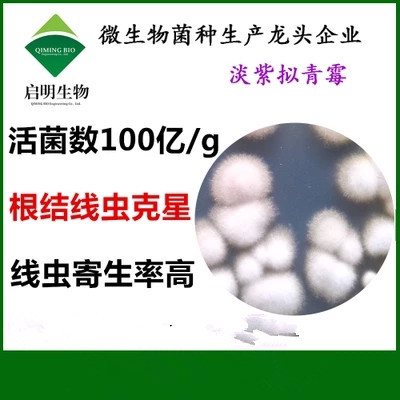
淡紫拟青霉菌根结线虫 滴灌微生物菌蔬菜柑橘大姜洋葱微生物菌剂

淡紫拟青霉菌

线虫克星82淡紫拟青霉
图片尺寸640x1138
发酵物酿酒酵母细黄链霉菌纤维素酶放线菌淡紫拟青霉里氏木霉长枝木霉
图片尺寸1440x1080
详细聊一聊淡紫拟青霉菌与根结线虫
图片尺寸500x375
实验室状态下的淡紫拟青霉菌落
图片尺寸600x397
活菌50亿淡紫拟青霉紫孢菌厂家直销农作物根结线虫毛囊用1000g袋
图片尺寸300x300
淡紫拟青霉
图片尺寸1000x1228
淡紫色拟青霉
图片尺寸394x235
淡紫拟青霉菌根结线虫 滴灌微生物菌蔬菜柑橘大姜洋葱微生物菌剂
图片尺寸400x400
淡紫拟青霉(又名:淡紫紫孢菌),是一种优异的生防真菌,用于防 - 抖音
图片尺寸1280x2780
基本概况淡紫拟青霉属于内寄生性真菌,是一些植物寄生线虫的重要天敌
图片尺寸350x350
淡紫拟青霉:丝孢菌科拟青霉属微生物
图片尺寸658x370
绿陇防线宝根结线虫微生物菌剂淡紫拟青霉淡紫紫孢菌
图片尺寸1024x1365
淡紫拟青霉
图片尺寸640x320
根结线虫,胞囊线虫克星 淡紫拟青霉属于内寄生性真菌,是一些
图片尺寸386x511
一株淡紫拟青霉菌株及其应用和从中提取毒素的方法与流程
图片尺寸1000x390
淡紫拟青霉生物有机肥功能菌防线虫菌剂
图片尺寸500x500
淡紫拟青霉菌
图片尺寸720x1184
2,淡紫拟青霉孢子萌发后会产生菌丝,这种菌丝可以穿透线虫的卵壳,幼虫
图片尺寸800x320
哈茨木霉菌淡紫拟青霉.
图片尺寸1440x2160
福建三明永安市淡紫拟青霉淡紫紫孢菌
图片尺寸750x750